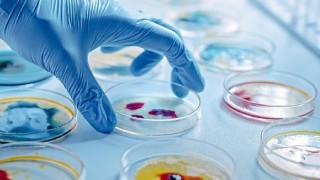

Ege Üniversitesi (EÜ) Gözlemevi Uygulama ve Araştırma Merkezi her yaştan ve eğitim düzeyinden insana uzay ve astronomi konularında konferanslar, geziler, gözlem etkinlikleri gibi çok farklı alanlarda eğlenceli eğitim hizmetleri veriyor. Uzay tutkunlarının yoğun ilgiyle ziyaret ettiği EÜ Gözlemevi, yaptığı bilimsel araştırmalar, düzenlediği ‘bilim-toplum’ temalı etkinlikleri ve verdiği eğitimler ile Ege Üniversitesinin topluma hizmet misyonuna katkı sağlamaya devam ediyor.
“Türkiye’nin en büyük ikinci gözlemevi”
Gözlemevinde astronomi ile ilgili her konuda çalışmalar yürütüldüğünü belirten Fen Fakültesi Astronomi ve Uzay Bilimleri Bölümü Astrofizik Anabilim Dalı öğretim üyesi ve Gözlemevi Uygulama ve Araştırma Merkezi Müdürü Doç. Dr. Hasan Ali Dal, “1963 yılında kurulum hazırlıklarına başlanılan ve 1965 yılında ilk değişen yıldız gözlemiyle kuruluşu tamamlanan EÜ Gözlemevi, Türkiye’nin ilk iki gözlemevinden birisi. İlk kuruluş yıllarında amacı, birbiri etrafında dolanan örten çift yıldızların gözlemi ve bu gözlemlerde temel olarak birbiri etrafında dönerken dönemselliğindeki değişimlerin belirlenmesi üzerine inceleme yapmaktı. Araştırma Merkezi, Rektörlüğe Bağlı Enstitü ve Fen Fakültesine bağlı laboratuvar olarak faaliyetlerine devam etti. Günümüzde Astronominin her alanında gözlemin yapıldığı bir merkez olan EÜ Gözlemevi, Türkiye’nin en büyük ikinci gözlemevi olma niteliği taşıyor. Rektörümüz Sayın Prof. Dr. Necdet Budak’ın destekleri ile fiziki ve teknolojik altyapısı yenilenerek güçlendirilen Gözlemevi’nde, yapılan çalışmaların hızlı bir şekilde topluma yansıması için Bilim-Toplum etkinliklerine büyük önem veriliyor. Bilim toplum etkinliklerinin yanında akademik çalışmalarımız da devam ediyor” dedi.
“Türkiye’nin en büyük göktaşı koleksiyonu EÜ Gözlemevinde”
Astronomi alanına merak duyan herkese eğitim verdiklerini söyleyen Doç. Dr. Dal, “Merkezimizde şu an yürürlükte olan 19 sosyal sorumluluk projesinin yanı sıra doğayı, uzayı keşfetmeleri ve tanımaları için çeşitli gruplara yönelik programı önceden yapılmış eğitimlerimiz bulunuyor. Yılda yaklaşık 1200 öğretmenimize yönelik, uzay ve gezegenler hakkında kapsamlı bir eğitim programımız var. Katılımcılarımıza astronomi, doğa ve uzay ile iç içe bir eğitim alma şansı sunuyoruz. Gelen ziyaretçilerimiz, Türkiye’nin en büyük göktaşı koleksiyonunu EÜ Gözlemevinde görebilme fırsatı buluyor. Her yıl Mayıs ve Eylül aylarında 2’şer günlük çadırlı kamp etkinliğiyle ziyaretçilerimizi ağırlıyoruz. Randevulu sistem ile her zaman açık olan Gözlemevine her yaştan bilim aşığı tüm ziyaretçilerimizi bekliyoruz” diye konuştu.
“Milli Uzay Programı’ kapsamında çalışmalar yürütüyoruz”
Doç. Dr. Dal, “2021 yılında Cumhurbaşkanlığı tarafından açıklanan ‘Milli Uzay Programı’ kapsamında önemli çalışmalar yürütüyoruz. Gözlemevimiz bu projede yere yakın gökcisimleri ve uzay havası gözlemi konularında çalışmalarına devam ediyor. Bilimde öncü üniversite olarak, Türkiye Yüzyılı vizyonuyla yürütülen bu projede Ege Üniversitesini adını öne çıkarmaya hedefliyoruz” diye konuştu.
Kaynak: (BYZHA) Beyaz Haber Ajansı

Yorum Yazın